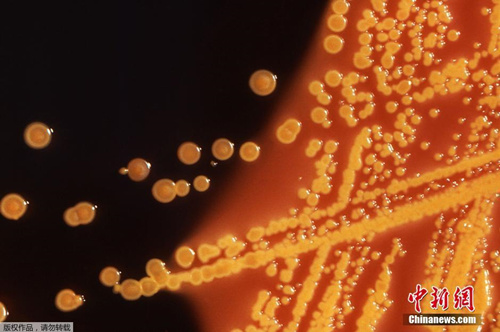

据外媒报道,美国卫生官员26日报告称,美国发现首例对所有已知抗生素有抵抗力的细菌感染病例,如果这种超级细菌传播,可能造成日常感染的严重危险。这种超级细菌自身首先是被名为质粒(plasmid)的小DNA分子感染,质粒携带可对粘杆菌素产生抗性的名为mcr-1的基因。而粘杆菌素是被专门用来对抗“噩梦细菌”的一种抗生素。图为显微镜下携带mcr-1基因的大肠杆菌。
据外媒报道,美国卫生官员26日报告称,美国发现首例对所有已知抗生素有抵抗力的细菌感染病例,如果这种超级细菌传播,可能造成日常感染的严重危险。这种超级细菌自身首先是被名为质粒(plasmid)的小DNA分子感染,质粒携带可对粘杆菌素产生抗性的名为mcr-1的基因。而粘杆菌素是被专门用来对抗“噩梦细菌”的一种抗生素。图为显微镜下携带mcr-1基因的大肠杆菌。